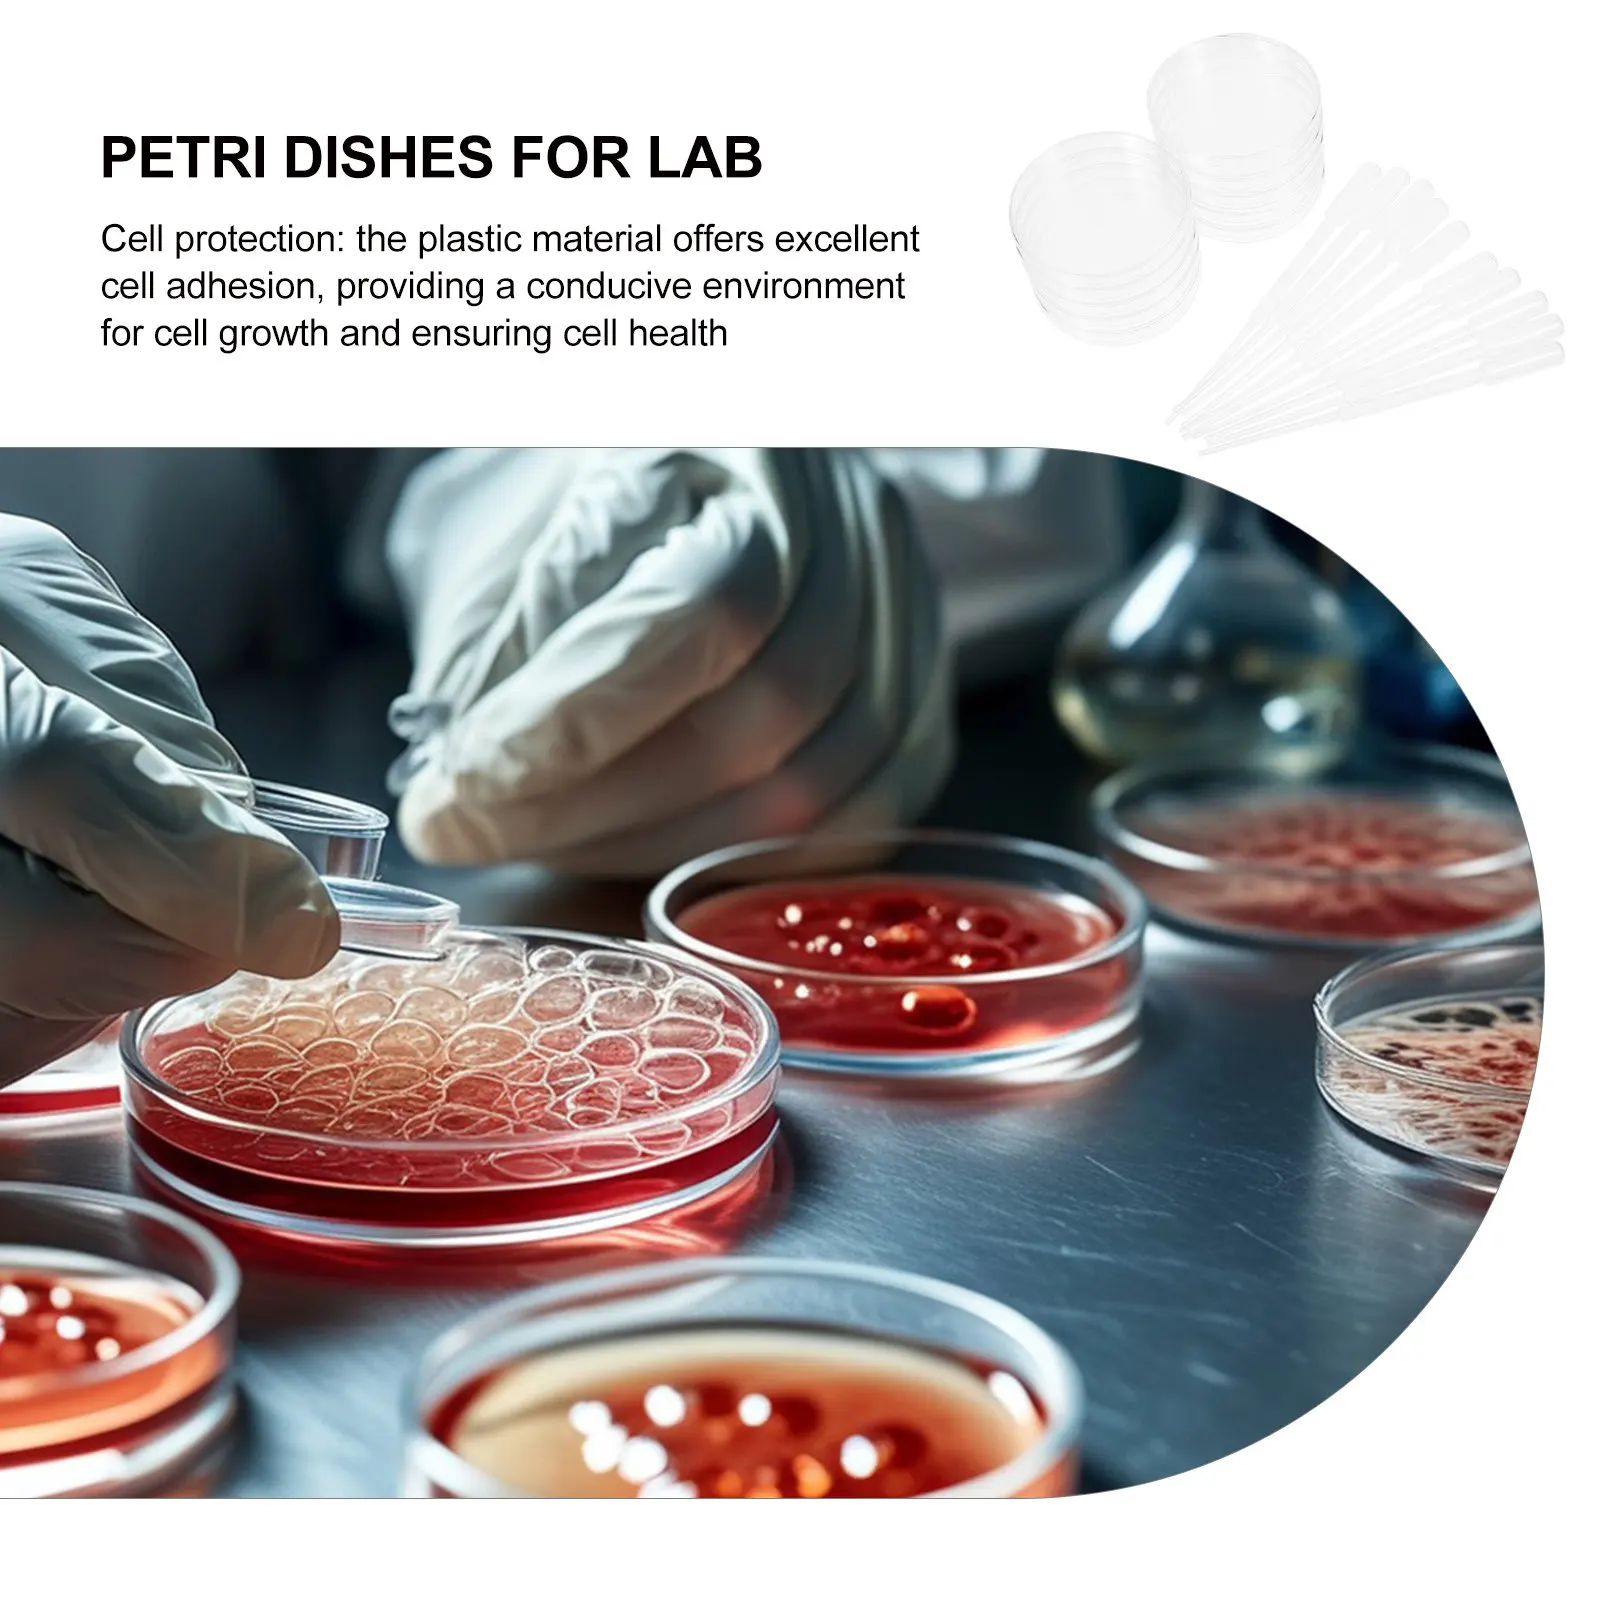
1Set Plastic Petri Dishes with Lids for Cell Culture Clear Deep Dish Set Includes Plastic Droppers Scientific

OOWLIT Polarized Lenses Replacements For Rudy Project Genetyk Sunglasses
Price history chart & currency exchange rate
Customers also viewed

$17.91
1pc Fashion Grey/water-resistant Polyester Folding Shower Curtain, Laminated Fabric, Includes 12 Hooks, Home Decor Curtain, Woven, Unlined, Clean
temu.com
$25.98
InsGoth Steampunk Gothic High Low Dress for Women Vintage Floral Lace Dress Spaghetti Strap Lolita Dress Lace Up Corset Dresses
aliexpress.com
$26.81
for Tesla Model Y 2023 Storage Box Underseat Drawer Hidden Type Organizer TPE Texture Car Storage Space For Model Y Accessories
aliexpress.com
$102.05
Leecabe 23CM/9inches Shiny PU Patent Upper Fashion Lady High Heel Platform Thigh High Boot Pole Dance Boots
aliexpress.com
$25.48
36Pcs/lot Cute Funny Fruit Strawberry Gel Pens Pineapple Kawaii Stationery Store Ballpoint Rollerball Back to School Stuff Thing
aliexpress.com
$27.58
Электрическая вакуумная упаковочная машина, вакуумная упаковочная машина, новая упаковочная машина для хранения пищевых продуктов, европе...
aliexpress.ru
$10.81
5 шт./набор 1:12 Миниатюрный Кукольный домик в Европейском стиле, обеденный стол, стул, железная мебель, Декор для дома и сада, игрушка, аксессуары для кукольного домика
aliexpress.ru
$11.22
Боксеры мужские из мягкого хлопка, нижнее белье со средней талией, эластичные модные трусы с принтом, брифы, нижнее белье, трусы, 2 шт. нижнее белье мужское трусы мужские бесшовные мужское нижнее белье мужские трусы бо
aliexpress.ru
$7.98
Bling чехол рулевого колеса автомобиля, легко установить ступицы автомобиля, не сдвигается чехол на руль для Renault Clio X4 X45
aliexpress.ru
$6.88
Крышка для автомобильной слепой панели, сменная часть для автомобильной консоли, крышка для слепой панели, пылезащитная крышка, крышка для VOLVO C30 C70 S40 V50
aliexpress.ru
$14.98
Женские шикарные сандалии; Женские летние сандалии в римском стиле с кристаллами; Женские Вьетнамки в богемном стиле; Пляжная обувь на плоской подошве; Женская обувь размера плюс 35-43; 2020
aliexpress.ru
$2.15
Запонки для мужчин, запонки из латуни для открывания красного вина, оптом и в розницу
aliexpress.ru
$5.48
Nurse Uniform Women Scrubs Short Sleeve Cartoon Animal Print Aesthetic Nursing Working Uniform Shirts Nurse Acessorios Femininos
aliexpress.com
$7.63
Для XCT XCM XCR вилка с регулируемой кнопкой предварительной нагрузки Велосипедная вилка для горного велосипеда запчасти для ремонта
aliexpress.com
$20.80
Glass motor removal tool Window Generator Adjust Wrench For BMW Mini Cooper R50 R52 R53 S R53 513240
aliexpress.com
$13.45
Игровой коврик для мыши, коврик для мыши, игровой мягкий коврик для мыши из натурального каучука, офисный коврик для клавиатуры, коврик для мыши, коврик для мыши
aliexpress.ru
$4.25
Suit to AMAOE Applicable to Samsung Exynos1080/ tin net /CPU/ upper and lower one/steel net
aliexpress.com
$4.74
POYATU Audio Cable For Sennheiser HD598 HD558 HD518 HD 598 Headphone Cables Replacement Cord With Mic Remote For IPhone Andriod
aliexpress.com
$9.77
No.1358 Painting By Numbers DIY Oil Coloring Paint By Numbers Set Gift Drawing By Numbers Canvas Decor New Arrivals
aliexpress.com
$14.25
NEW 2020 Motorcycle For SYM MAXSYM TL 500 TL500 Front Phone Stand Holder Smartphone Phone GPS Navigaton Plate Bracket Wireless
aliexpress.com
$7.50
10ml 15ml 20ml White Essential Oil Bottles With Glass Pipettes Empty Glass Perfume Bottles For Aromatherapy Cosmetic Containers
aliexpress.com
$10.56
Honey Dipper Mini Sticks Wooden Stick Honeycomb Spooninch Stirrer Stirrers Spoons Stir Wood Bulk Dippers 3Inch Stirring Comb Jar
aliexpress.com
$3.41
12Sets/72pcs Rubber Fishing Bobber Stopper Set 6-in-1 Yellow Red Oval Space Beans Floats for Rigging Fishing Accessories
aliexpress.com
$9.77
1Set Plastic Petri Dishes with Lids for Cell Culture Clear Deep Dish Set Includes Plastic Droppers Scientific
aliexpress.com
$39.20
Пробуждение Артефакт Настольный Декор Компьютерная Клавиатура Аксессуары Подарок Maclock Ретро Часы Креатив Будильник Студенческий Специальный
aliexpress.ru
$5.37
Premium Horizontal Engine Cylinder Head Gasket Kits Specifically Engineered for 70cc ATV and Dirt Bikes
aliexpress.com












